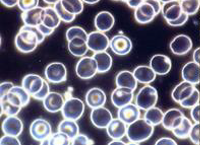
Dunkelfeldbild

Ausbildung: Vitalblutuntersuchung im Dunkelfeld.
Fotografische und diagnostische Transparenz in der Dunkelfeldmikroskopie:
a. Untersuchung nach Prof. Enderlein
b. Säurestatus nach Pfleiderer©®
Normalbefund:
Degenerative Entgleisung:
Die Dunkelfeldmikroskopie ist keine
Symptom-Therapie, sondern eine Milieutherapie!!
Schon Prof. Vincent sagte:
„Beobachte das Milieu einer Erkrankung, entziehe ihr den Nährboden, und die Krankheit stirbt von selbst ab.“
Der besondere Fokus in der Dunkelfeldmikroskopie (DFM) liegt in der Beobachtung des Blutes, das zuerst aktuell angeschaut und diagnostiziert wird. Dem folgen weitere Beobachtungen über Stunden und Tage. Erst dieses mehrmalige Schauen lässt eine kompetente und umfassende Diagnose zu.
Es ist bekannt, dass das Blutmilieu entscheidend mit wirkt an dem Gestaltwandel von Mikroorganismen n. Enderlein.
Veränderung wird ausgelöst u.a., durch Übersäuerung, Sauerstoffdefizit, Mangelernährung, Zahnherden und Darmfehlbesiedlung.
Die wichtigsten Mikroorganismen nach Prof. Enderlein sind der „Mucor racemosus fresen“, der für die Blutfliesseigenschaften zuständig ist, sowie der „Aspergillus niger“, der die paratuberculinischen Krankheiten einschließt.
In der Sanumtherapie
nach Prof. Enderlein, die inhaltlich zur Dunkelfeldmikroskopie gehört, werden heilungsfördernde niedervalente Wuchsformen (Chondrite) des Mucor racemosus fresen und Aspergillus niger als isotherapeutische Heilmittel eingesetzt: Mucokehl und Nigersan.
Für Einsteiger sowie auch für Fortgeschrittene ist es nicht immer leicht das Blut-Milieu angemessen zu beurteilen. Infolgedessen wurde von mir der geschützte „Säurestatus ST nach Pfleiderer“
© entwickelt, der das Blut-Milieu in die Stadien 1-4 einteilt. Aufgrund dieser Differenzierung steht neben der Dunkelfeldmikroskopie-Diagnostik ein zusätzliches, vergleichendes Meta-Screening (Kontrolltest) zur Verfügung, das eine „Aufwärtsentwicklung sowie Abwärtsentwicklung“ im Sinne „Enderleins“ dokumentiert.
Beide Untersuchungsmethoden, die Dunkelfeldmikroskopie und der Säurestatus nach Pfleiderer
©® ergänzen sich bestens als Verlaufs- und Therapiekontrolle, u.a. bei
Degenerativen Entgleisungen im Blut (Endobiose)
Mesenchymaler Azidose nach Sander
Erschöpfung der Blutpuffersysteme
Stoffwechselstörungen
Reduzierte Fließeigenschaften des Blutes (Viskosität), Sauerstoffdefizit
Beziehung zwischen Blut und Fehlbesiedlung des Darmes (Dysbiose)
Ausbildung: Vitalblutuntersuchung im Dunkelfeld.
Fotografische und diagnostische Transparenz in der Dunkelfeldmikroskopie:
a. Untersuchung nach Prof. Enderlein
b. Säurestatus nach Pfleiderer©®
Normalbefund
Degenerative Entgleisung
Die Dunkelfeldmikroskopie ist keine Symptom-Therapie, sondern eine Milieutherapie!!
Schon Prof. Vincent sagte:
„Beobachte das Milieu einer Erkrankung, entziehe ihr den Nährboden, und die Krankheit stirbt von selbst ab.“
Der besondere Fokus in der Dunkelfeldmikroskopie (DFM) liegt in der Beobachtung des Blutes, das zuerst aktuell angeschaut und diagnostiziert wird. Dem folgen weitere Beobachtungen über Stunden und Tage. Erst dieses mehrmalige Schauen lässt eine kompetente und umfassende Diagnose zu.
Es ist bekannt, dass das Blutmilieu entscheidend mit wirkt an dem Gestaltwandel von Mikroorganismen n. Enderlein.
Veränderung wird ausgelöst u.a., durch Übersäuerung, Sauerstoffdefizit, Mangelernährung, Zahnherden und Darmfehlbesiedlung.
Die wichtigsten Mikroorganismen nach Prof. Enderlein sind der „Mucor racemosus fresen“, der für die Blutfliesseigenschaften zuständig ist, sowie der „Aspergillus niger“, der die paratuberculinischen Krankheiten einschließt.
In der Sanumtherapie
nach Prof. Enderlein, die inhaltlich zur Dunkelfeldmikroskopie gehört, werden heilungsfördernde niedervalente Wuchsformen (Chondrite) des Mucor racemosus fresen und Aspergillus niger als isotherapeutische Heilmittel eingesetzt: Mucokehl und Nigersan.
Für Einsteiger sowie auch für Fortgeschrittene ist es nicht immer leicht das Blut-Milieu angemessen zu beurteilen. Infolgedessen wurde von mir der geschützte „Säurestatus ST nach Pfleiderer“
© entwickelt, der das Blut-Milieu in die Stadien 1-4 einteilt. Aufgrund dieser Differenzierung steht neben der Dunkelfeldmikroskopie-Diagnostik ein zusätzliches, vergleichendes Meta Screening (Kontrolltest) zur Verfügung,
das eine „Aufwärtsentwicklung sowie Abwärtsentwicklung“ im Sinne „Enderleins“ dokumentiert.
Beide Untersuchungsmethoden, Dunkelfeldmikroskopie und Säurestatus nach Pfleiderer
©® ergänzen sich bestens als Verlaufs- und Therapiekontrolle, u.a. bei
Degenerativen Entgleisungen im Blut (Endobiose)
Mesenchymale Azidose nach Sander
Erschöpfung der Blutpuffersysteme
Stoffwechselstörungen
Reduzierte Fließeigenschaften des Blutes (Viskosität), Sauerstoffdefizit
Beziehung zwischen Blut und Fehlbesiedlung des Darmes (Dysbiose)